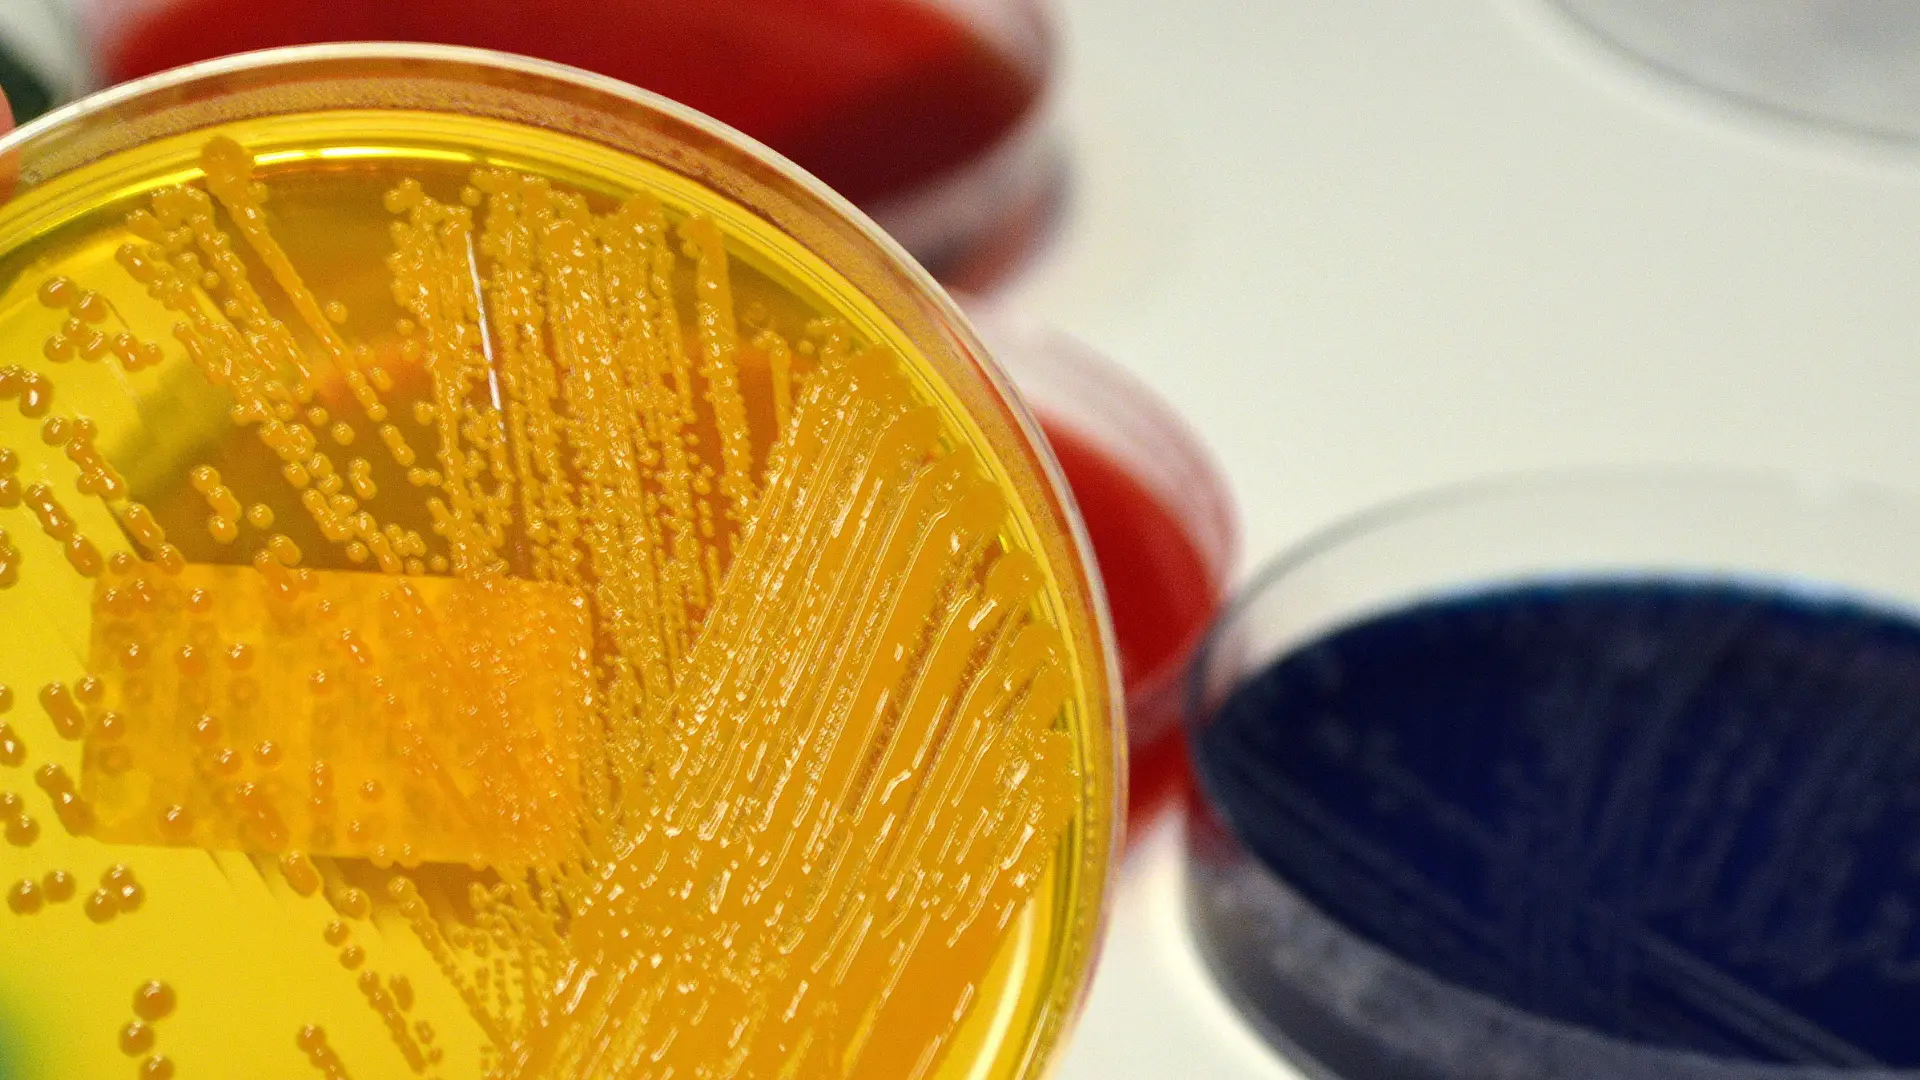

Pek çok yüzey üzerinde oluşum gösterebilen küçük yapıdaki mikroorganizmalara verilen isimdir. Her ne kadar tek şekilde yaşayabilme özelliğine sahip olsalar bile daha çok topluluk halinde yüzeylerde var olmaktadır. Jel kıvamında olan bir yapı içerisinde kendi kendini üretmektedir. Genel olarak bir yüzeye veya birbirine tutunmuş şekilde olmaktadır. Yaşayan veya yaşamayan varlıklar üzerinde çoğalabilme eylemi göstermektedir. Canlı veya cansız varlıklar üzerinde var olabilmesi ancak birçok koşula bağlı olmaktadır. Uygun koşulların meydana gelmesi durumunda ise biyofilm tabakası oluşmaktadır. Koşullar ise birçok etkene bağlı olarak değişkenlik gösterebilir. İsterseniz görevlerine, nerede oluştuğuna ve nerelerde oluştuğuna daha yakın bir açıdan göz atalım.
Biyofilm Tabakası Nedir?

Hayatımızın birçok alanında rahatlıkla karşı karşıya gelebileceğimiz oluşumlardır. Genel olarak bir yüzey içinde ve kendilerinin üretmiş olduğu jelimsi yapıda var olmaktadırlar. Mikroorganizmalar topluluğu olarak da ifade edilmektedir. Jelimsi yapının içerisinde polisakkarit içeriği bulunmaktadır. Buna ek olarak, ortamın uygun koşula gelmesi sonrasında ise beklenen çoğalma gerçekleşir. Genel olarak bakterilerin korunması açısından büyük öneme sahiptir.
Tabakanın oluşması birçok faktöre göre değişiklik göstermektedir. Bakterilerin mevcut yüzeye ne oranda bağlandığı, bulunduğu ortamın sıcaklığı, ortamın pH değeri, bakterinin hangi tür olduğu bu faktörlerden bazılarıdır. Bunlara ek olarak, hücre duvarının mevcut olan yapısı, bakterilerin toplam sayısı, yüzeyin özellikleri, hücrelerin hareketlilik durumları, ortam da bulunan besinlerin içerik yönü, besin miktarı ve iyon konsantrasyonu gibi birçok etken biyofilm oluşmasında etkili olan temel noktalardır. Bu koşullar gerekli olduğu şekilde sağlanması durumunda tabaka oluşumu da meydana gelmektedir.
Biyofilm Görevi Nedir?
Tabakanın sahip olduğu görevler oldukça kritik bir öneme sahiptir. Çünkü bakterilere maruz kaldığı olumsuz etkenler dolayısı ile zarar gelebilmektedir. Özellikle bazı çevresel etkenler söz konusu olduğu zaman bakteriler korunmaya ihtiyaç duymaktadır. Bu çevresel koşullar ise ortamın nem oranı, ortamın ısısı, pH oranı ve zararlı güneş ışınlarına maruz kalınmasıdır. Sahip olduğu nitelikler sayesinde bu tür çevresel etkenlere karşı bakterilerin korunmasına yardımcı olur. Tabaka bu zararlı çevresel koşullardan bakterilerin korunmasına katkı sağlamaktadır. Farklı avantajları da söz konusu olmaktadır. Besinlerin depolanmasını sağlamak da biyofilm tabakası görevleri arasında yer almaktadır. Bunun yanı sıra atıkların kolay şekilde uzaklaşmasını da sağlamaktadır. En çok bilinen ve önemli olan görevleri genel olarak bu kapsamda yer almaktadır. Besinler ve bakteriler açısından en önemli görevleri genel olarak bu üç madde kapsamında yer alır. Ancak sadece bunlarla sınırlı değildir. Farklı görev ve avantajları da bulunmaktadır. Yani bakteriler için kritik öneme sahiptir demek oldukça doğru bir tanım olacaktır.
Biyofilm Nerede Oluşur?

Biyofilm oluşumu ancak uygun koşullar sağlandığı zaman gerçekleşmektedir. Oluşum yeri birçok açıdan önemlidir. Çünkü her yüzey biyofilm oluşumu için uygun ortamı ve koşulu sağlamamaktadır. İyi bir tutunmanın gerçekleşmesi için daha çok sulu ortamlar gerekmektedir. Çünkü genel olarak sulu yüzeylere oluşmaktadır. Ancak bakterilerin olduğu herhangi bir ortamda da meydana gelebilmektedir. Bakterilerin uygun tutunma ortamı olması durumunda, sonradan bakterilerin tutunmasını etkileyen maddeler çerçevesinde ortamda bakteri olan herhangi bir sulu yüzey içerisinde oluşmaktadır. Biyofilm oluşum yerleri genel olarak bu şekilde özetlenebilmektedir. Örnek vermek gerekirse, su sistemi, mukozal yüzey, kaya, besinler, besinlerin paketlenen yüzey kısımları, besinlerin üretim yüzeyi, deri olan tıbbi alanda kullanılan mekanizmalarda oluşum göstermektedir. Doğada ise biyotik ve abiyotik olarak adlandırılan tüm yüzeylerde oluşum gösterme özelliği bulunmaktadır. Genel olarak birçok yüzey biyofilm oluşumu için uygun bir ortam halini alabilmektedir. Ancak biyofilmin oluşması için yüzeyde gereken tüm faktörlerin olması da önemli bir noktadır.
Biyofilm Nerelerde Kullanılır?

Biyofilm hakkında en çok merak edilen noktalardan biri de nerede kullanılacağıdır. Çünkü bakteriler açısından sağladığı faydalar göz önüne alındığı zaman nerede kullanılacağı da merak edilmektedir. Ancak bu tek bir alanla sınırlı değildir. Birçok alanda ve farklı dallarda da kullanılmaktadır. Biyofilm oluşumunun en çok gözlemlendiği ve görüldüğü alanlar genel olarak tıptır. Birçok açıdan kullanımı gerekli ve önemlidir. Biyofilm kullanılan alanlar şu şekilde olmaktadır:
- Protez kalp kapacıkları
- Santral venöz kateterler
- İdrar sondaları
- Kontak lens
- İntrauterin cihazlar
- Kalıcı tıbbi cihazlar
Tıpta yaygın olarak kullanılan noktalar bu şekildedir. Fakat farklı alanlarda farklı kullanım yerleri söz konusu da olabilmektedir. Biyofilm tabakası endüstriyel olarak oldukça geniş kullanım alanlarında yer bulması göze çarpan detaylar arasında yer almaktadır.
Sık Sorulan Sorular
Biyofilm tabakası oluşturan bakteriler nelerdir?
Biyofilm oluşumunda birçok farklı bakteri türü etkilidir. Bunlardan bazıları pseudomonas aeruginosa, staphylococcus epidermidis, escherichia coli, bacillus cereus, vibrio choleraedir. Biyofilm oluşumunda farklı bakteri türleri etkilidir ve bu türler bölgesel farklılıklar gösterebilir.
Biyofilmin yarattığı sorunlar nelerdir?
Biyofilmin oluşması birçok soruna neden olabilir. İşte biyofilm tabakasının yaratabileceği olumsuz etkilerden bazıları: Mikrobiyal kirlilik, yüzey hasarı, kokular, sağlık sorunları, enerji ve gıda kaybı. Biyofilm, tabaka içinde yaşayan mikroorganizmaların büyümesi için ideal bir ortam sağlar. Bu, biyofilmin bulunduğu ortamlarda mikrobiyal kirliliğin artmasına neden olabilir. Bunun yanı sıra, yüzeylere zararlı asitler ve enzimler salgılar. Bu asitler ve enzimler, yüzeylerde kalıcı hasara neden olabilir ve malzemelerin ömrünü kısaltabilir. Biyofilm tabakası aynı zamanda, kötü kokuların kaynağı olabilir. Bu tabaka, organik maddelerin çürümesi sonucu ortaya çıkan kokulara neden olabilir. Bazı mikroorganizmaların büyümesini teşvik edebilir. Bu mikroorganizmalar, insanlara ve hayvanlara zararlı olabilir ve ciddi sağlık sorunlarına neden olabilir. Biyofilm, su ve hava geçişini engelleyebilir. Bu, ısıtma ve soğutma sistemlerinde enerji kaybına neden olabilir ve enerji maliyetlerini artırabilir. Son olarak ise gıdaların bozulmasına neden olabilir. Bu da gıda kaybına neden olabilir ve gıda endüstrisinde büyük bir sorun oluşturabilir.
Biyofilm tabakası nasıl önlenir?
Biyofilm, yüzeylerde biriken ve genellikle mikroorganizmaların büyümesine neden olan ince bir tabakadır. Su, toprak, çeşitli yüzeyler ve hatta insan ve hayvan vücutları dahil olmak üzere birçok yüzeyde meydana gelebilir. Biyofilm tabakasının oluşumunu önlemek için şu adımlar atılabilir: Yüzeyleri temiz tutun, yüzeyleri kurutun, yüzeylere antimikrobiyal kaplama uygulayın, havalandırma sağlayın ve yüzeyleri düzenli olarak dezenfekte edin.







